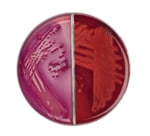

Search
- Home
- Shop All Products
- Uti Testing
Columbia Agar with Horse Blood/MacConkey Agar without Salt Biplate
Cultivate, isolate and identify a broad range of microorganisms while simultaneously detecting and enumerating coliform organisms with Thermo Scientific™ Oxoid™ Columbia Agar with Horse Blood/MacConkey Agar without Salt Biplate.
